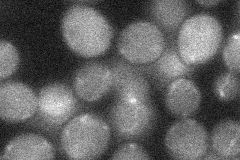
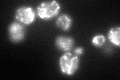
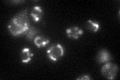

View description
Subunit VII of cytochrome c oxidase, which is the terminal member of the mitochondrial inner membrane electron transport chain
Localization:
Intensity:
Fold change:
Significance:
-
C’ GFP library in SD

mitochondria71.53 -
N' NOP1pr-GFP in SD

mitochondria53.5335 -
N' TEF2pr-mCherry in SD

mitochondria68.3338 -
N' NATIVEpr-GFP in SD
cell periphery21.4065 -
N' TEF2pr-VC and Cyto-VN in SD

#N/A0 -
C’ GFP library in SD+DTT
mitochondria59.480.83No -
C’ GFP library in SD+H2O2

mitochondria66.210.92No -
C’ GFP library in Starvation Media
mitochondria79.441.11No -
C’ GFP library on the background of Pup2-DaMP

mitochondria -
C’ GFP library on the background of CCT mutant

mitochondria55.97740.7824No
